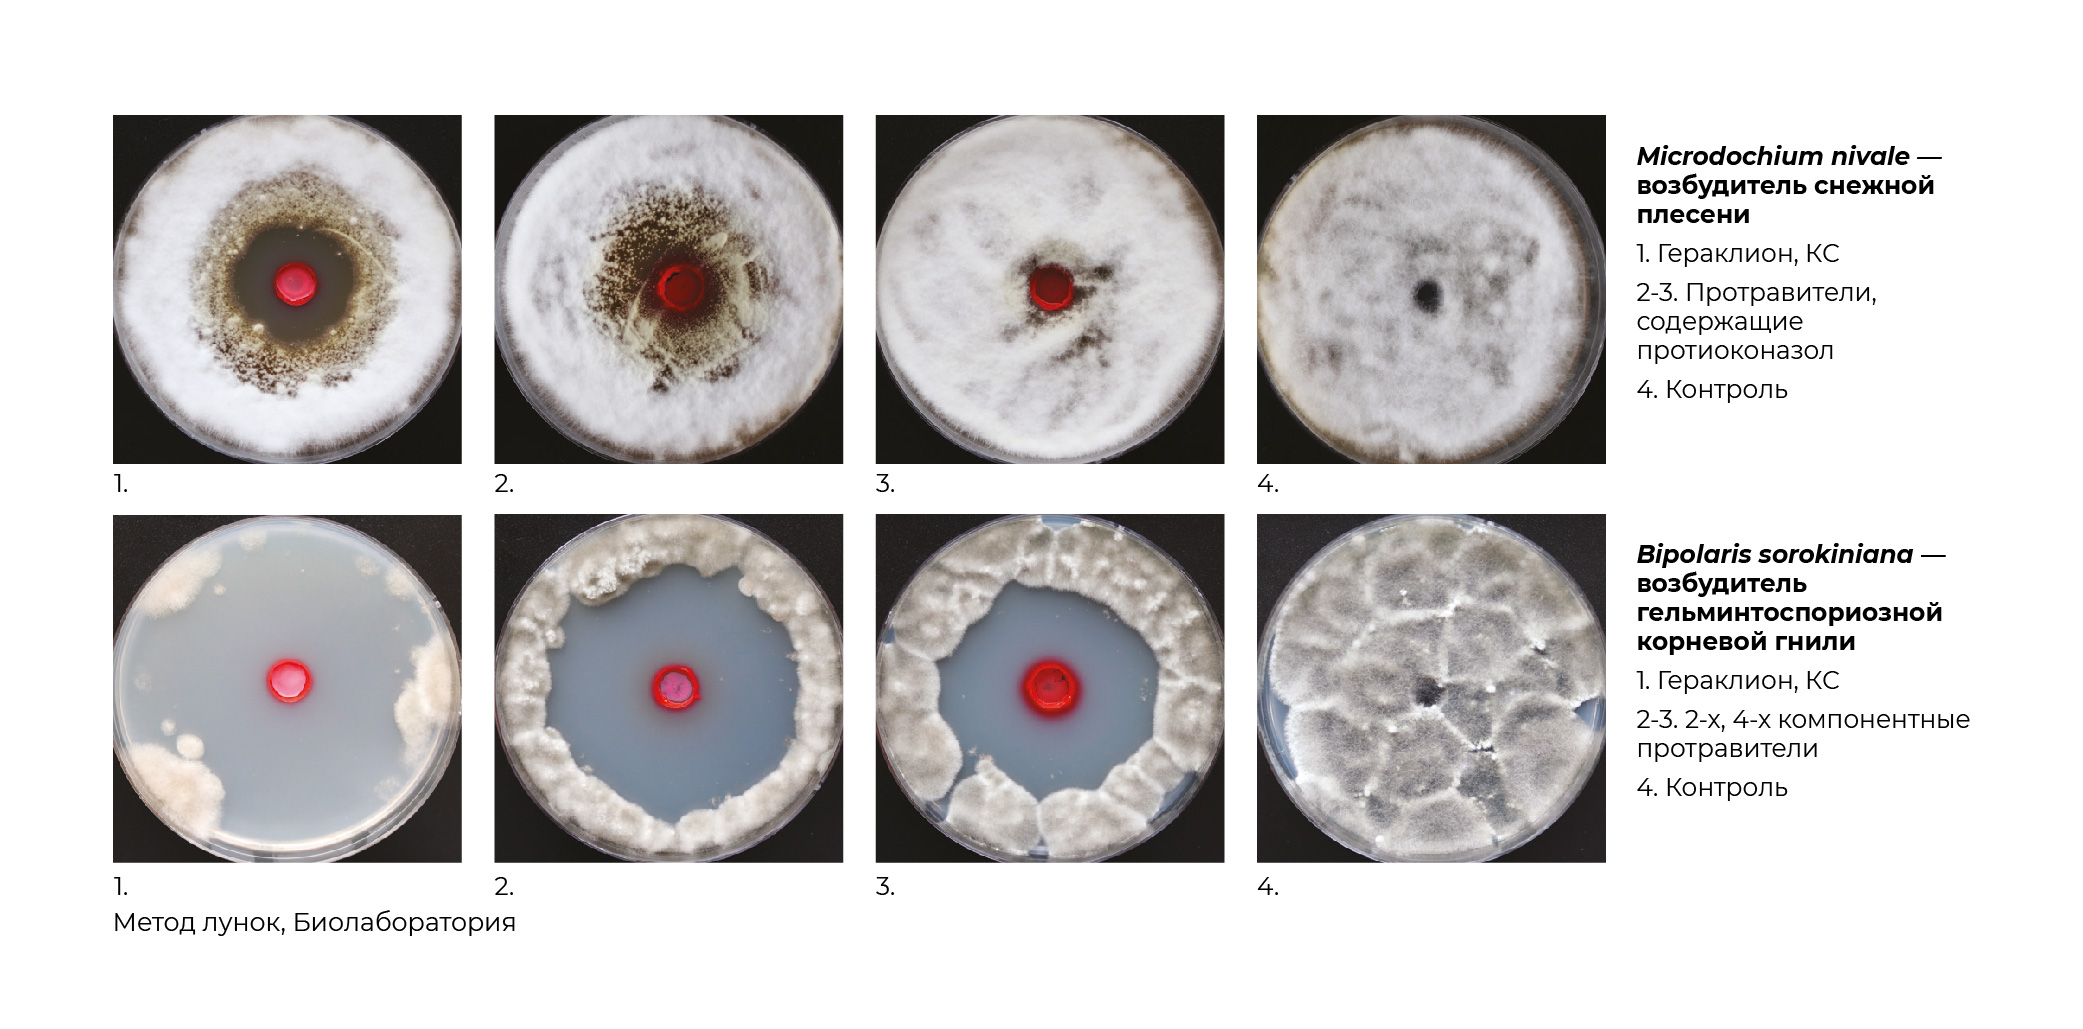
Geraklion_ (1).jpg Geraklion_ (1).jpg

Гераклион, КС
концентрат суспензии
400 г/л тирама + 25 г/л тебуконазола + 15 г/л азоксистробина
Уникальный контактно-системный фунгицидный протравитель с бактерицидным действием для обработки семян зерновых культур, сои, гороха, подсолнечника.
Преимущества:
- Самый эффективный протравитель семян в своем классе за счет эмергенции 3-х компонентов - появление антибактериального эффекта в сочетании с фунгицидной защитой
- Расширенный спектр действия на патогены, включая оомицеты
- Дезинфекция почвы вокруг семенного ложа
- Активное влияние на биологические и физиологические процессы растений – мощный стимулирующий эффект
- Экономичность и высокий результат защиты
Действие препарата
Регламент применения
Общая информация
Лабораторные результаты
Полевые результаты
Отзывы о товаре
КФХ Поздняков Е.В., Воронежская область
глава КФХ
Сотрудничаем с компанией "Щелково Агрохим" более 5 лет. Препараты "Щелково Агрохим" мне нравятся, коллектив сплоченный, работает как одна команда. Особенно мне нравятся протравители, виден результат. Семена озимой пшеницы протравливал препаратом Гераклион, КС, предшественник зерновые. Получил чистую корневую систему и проростки без болезней. Урожай свыше 45 ц/га, доволен.